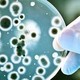
Microbios microbiologia

-
*Propone Teoría de Generación Espontanea.
*Descubre el reino vegetal y reino animal. -
*Atribuye las enfermedades a seres vivos diminutos, no puede comprobarlo.
-
*Realiza por primera vez observaciones mediante un microscopio creado por él mismo.
*Describe las bacterias. -
*Rechaza la Teoría de Generación Espontanea
-
*Sospecha sobre los patógenos de la peste.
-
*Proporciona la nomenclatura universal que permite clasificar a las plantas animales (Taxonomía).
-
*Divide la naturaleza en tres reinos: Animal, Vegetal y Mineral.
*Aplica nomenclatura binominal por género y especie para el estudio de los seres vivos. -
*Inicia sus investigaciones demostrando que los gérmenes se propagan por el aire, rechazando así la Teoría de la Generación Espontánea.
-
*Realiza aportes con respecto a la Fermentación láctica y la Pasteurización.
-
*Relaciona todas las formas de vida mediante un mapa genealógico.
*Introduce términos de clasificación biológica como: philogenia, phylum y ecología
*Propone una nueva clasificación de los reinos e introduce términos taxonómicos -
*Descubre vacuna contra la Rabia.
-
*Descubre bacteria con forma de bacilo(Bacteria de la Tuberculosis).
*Obtiene los primeros cultivos puros de bacterias, descubre las técnicas de preparación y tinción de bacterias.
*Inventa la tuberculina. Fracasa para eliminar la tuberculosis pero sirve para diagnosticarla. -
*Descubre el patógeno del cólera.
*Investiga la peste bubónica, la enfermedad del sueño, la fiebre de Texas y la Malaria. -
*Aplica por primera vez la vacuna contra la Rabia.
-
*Describe por primera vez el Reino Protista.
-
*Crea el sistema de los 5 reinos en el cual los procariontes se colocaban en el Reino Monera y los Eucariontes comprendían los otros 4 reinos.
-
*Destierra uno de los dogmas de la biología: la clasificación de los seres vivos en 5 grandes reinos, descubriendo así las arqueobacterias y propuso el árbol filiogentico universal, formado por 3 dominios de organismos bacterias, archea y eukarya.
Want to make a timeline like this?
Use Timetoast to turn dates, events, milestones, and phases into a clear visual timeline you can build and share. Timetoast is a timeline maker for work, school, research, and stories.